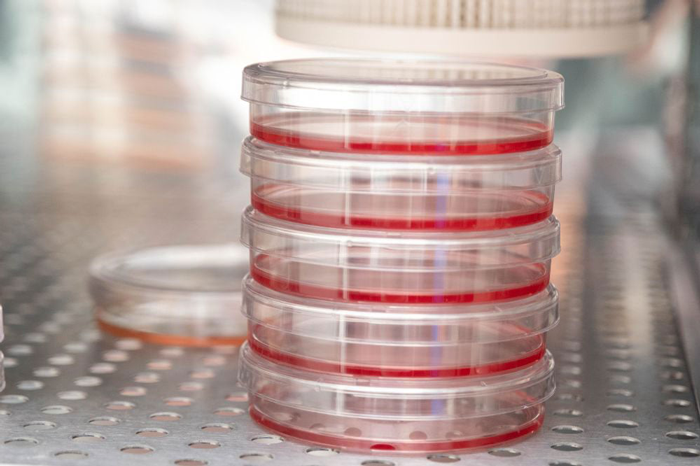
پلیتهای کشت سلولی در آزمایشگاه رودِر که دانشمندان بهتازگی بیان ژنها در سرطان پستان را در آن مطالعه کردند.

پژوهشگران سازوکار کنترلی فعالشونده در شرایط استرس را شناسایی کردهاند که به سلولهای سرطان پستان کمک میکند الگوی فعالیت ژنی خود را برای بقا و رشد بازتنظیم کنند.
سلولها اغلب با فشارهای محیطی روبهرو میشوند که میتواند به آنها آسیب بزند یا حتی موجب مرگشان شود. برای زندهماندن، آنها بهسرعت الگوی فعال بودن ژنها را تغییر میدهند تا بتوانند پاسخ حفاظتی لازم را ایجاد کنند. سلولهای سرطانی این چالش را شدیدتر تجربه میکنند، زیرا در ریزمحیطی رشد میکنند که بهطور طبیعی برای بقا دشوار است. با وجود این، آنها موفق میشوند رشد کنند و ژنهایی را فعال سازند که تشکیل تومورهای بزرگتر را تقویت کرده یا امکان گسترش به بخشهای دیگر بدن را فراهم میکند.
اینکه سلولهای سرطانی دقیقاً چگونه شرایط سخت را به یک مزیت تبدیل میکنند تاکنون روشن نبود. پژوهشگران دانشگاه راکفلر حدس میزدند پاسخ این معما در نحوهٔ تشخیص استرس توسط دستگاه رونویسی و تنظیم فعالیت آن نهفته است. یافتههای آنها اکنون یک «کلید مولکولی» در سلولهای سرطان پستان را شناسایی کرده است که جهت بیان ژنها را بهسوی رشد و تحمل بیشترِ استرس تغییر میدهد.
ران لین، نویسندهٔ اول و پژوهشگر همکار در آزمایشگاه بیوشیمی و زیستشناسی مولکولی دانشگاه راکفلر، میگوید: «این سازوکار در سطح رونویسی که پیشتر ناشناخته بود، به سلولهای سرطانی کمک میکند در شرایط استرسزا زنده بمانند؛ بنابراین هدفگیری آن میتواند مکانیزم حیاتی بقا که برخی سرطانها به آن وابستهاند را مختل کند. این نمونهای دیگر از چگونگی باز کردن مسیرهای درمانی امیدوارکننده توسط پژوهشهای پایه است.»
رابرت رودِر، رئیس آزمایشگاه، میافزاید: «ما دریافتیم این کلید مولکولی توسط یک کمپلکس رونویسی عمومی هدایت میشود که معمولاً برای همه ژنهای رمزکنندهٔ پروتئین لازم است. اما نکتهٔ غیرمنتظره این است که زیرواحدهای این کمپلکس میتوانند برای عملکردهای فیزیولوژیکی متعددی به کار گرفته شوند؛ از جمله عملکردی که به سلولهای سرطانی اجازه میدهد در محیطهای پرتنش زنده بمانند و رشد کنند.»
خدمات رونویسی ژنی
آنزیم RNA پلیمراز II، که به اختصار Pol II نامیده میشود، مسئول رونویسی ژنهای رمزکنندهٔ پروتئین در سلولهای یوکاریوتی است. رودِر دههها پیش Pol II را شناسایی کرد و این آنزیم اغلب همراه با کمپلکس مدیاتور، یک همفعالکنندهٔ بزرگ رونویسی متشکل از ۳۰ زیرواحد، فعالیت میکند تا فرآیند رونویسی که منجر به تولید RNA بالغ میشود را آغاز کند. تنظیمات اضافی نیز میتواند از طریق تغییرات پسارونویسی انجام شود که بر نحوهٔ بیان ژنها تأثیر میگذارد.
درون کمپلکس مدیاتور، یکی از زیرواحدهای مهم MED1 است. این بخش برای عملکرد صحیح Pol II در بسیاری از انواع سلولها ضروری است، از جمله سرطان پستان مثبت گیرندهٔ استروژن (ER+ BC)، که یکی از شایعترین اشکال سرطان پستان محسوب میشود.
تحقیقات پیشین دربارهٔ سرطان پستان مثبت گیرندهٔ استروژن (ER+ BC) در آزمایشگاه رودِر نشان داده است که تعاملات گیرندهٔ استروژن با MED1 موجب فعالسازی ژنها میشود؛ به حدی که میتواند داروهای امیدوارکنندهٔ ضد سرطان را ناکارآمد کند. این یافتهها باعث شد ران لین به این فکر بیفتد که آیا MED1 نقش مهمی در زنده ماندن و حتی رشد سلولهای سرطانی در شرایط استرسزا ایفا میکند یا نمیکند.
پلیتهای کشت سلولی در آزمایشگاه رودِر که دانشمندان بهتازگی بیان ژنها در سرطان پستان را در آن مطالعه کردند.
لین تصمیم گرفت بررسی کند که آیا MED1 استیله (acetylated) میشود یا نمیشود. استیله یک تغییر بیوشیمیایی است که شامل افزودن گروه استیل به پروتئین میشود و میتواند عملکرد آن را تغییر دهد. این تغییر بهطور فزایندهای بهعنوان عاملی مؤثر در توسعهٔ تومور، متاستاز و مقاومت دارویی شناخته میشود.
پس از مشخص شدن اینکه MED1 واقعاً استیله میشود، لین مرحله بعدی را بر درک تأثیر این تغییر بر عملکرد MED1 بهویژه در شرایط استرس سلولی متمرکز کرد. آنها سلولها را در معرض انواع مختلف شرایط استرس قرار دادند، از جمله هیپوکسی (کمبود اکسیژن)، استرس اکسیداتیو و استرس حرارتی است.
تغییر استیلها
پژوهشگران دریافتند که در شرایط استرس، پروتئینی به نام SIRT1 گروههای استیل را از MED1 طبیعی حذف میکند. این فرآیند که دیاستیلاسیون (deacetylation) نامیده میشود، باعث میشود MED1 بتواند با Pol II تعامل مؤثرتری داشته باشد و در نتیجه ظرفیت بالاتری برای فعالسازی ژنهای محافظتی ایجاد شود.
آنها همچنین نسخهای جهشیافته از MED1 ساختند که شش سایت استیله شدن خاص آن حذف شده بود و بنابراین قادر به استیله شدن نبود. سپس این پروتئین جهشیافته را در سلولهای سرطان پستان ER+ وارد کردند که در آنها MED1 بومی با استفاده از CRISPR حذف شده بود.
نتایج نشان داد که صرفنظر از اینکه MED1 چگونه دیاستیله میشود؛ چه از طریق شرایط استرسزا یا از طریق حذف قابلیت استیله شدن سلولهای سرطان پستان با MED1 دیاستیله شده تومورهایی سریعتر رشدکننده و مقاومتر در برابر استرس تشکیل میدهند.
منبع خبر : scitechdaily.com


































نظرات کاربران